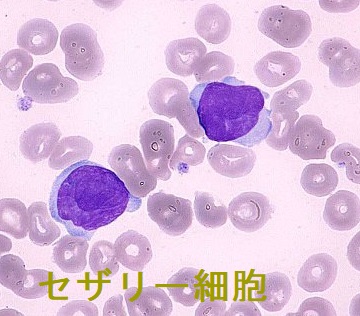
セザリー細胞 セザリー細胞

皮膚T細胞性リンパ腫,菌状息肉症,セザリー症候群,ベキサロテン(タルグレチン)と甲状腺[橋本病 長崎甲状腺クリニック 大阪]
甲状腺:専門の検査/治療/知見③ 橋本病 バセドウ病 甲状腺エコー 長崎甲状腺クリニック大阪
甲状腺専門の長崎甲状腺クリニック(大阪府大阪市東住吉区)院長が海外(Pub Med)・国内論文に眼を通して得た知見、院長自身が大阪市立大学(現、大阪公立大学) 代謝内分泌内科で得た知識・経験・行った研究、毎年恒例の日本甲状腺学会で入手した知見です。
長崎甲状腺クリニック(大阪)以外の写真・図表はPubMed等で学術目的にて使用可能なもの、public health目的で官公庁・非営利団体等が公表したものを一部改変しています。引用元に感謝いたします。
甲状腺・動脈硬化・内分泌代謝・糖尿病に御用の方は 甲状腺編 動脈硬化編 甲状腺以外のホルモンの病気(副甲状腺/副腎/下垂体/妊娠・不妊など) 糖尿病編 をクリックください。
長崎甲状腺クリニック(大阪)は甲状腺専門クリニックにつき、皮膚T細胞性リンパ腫,菌状息肉症,セザリー症候群の診療を行っておりません。それは血液内科の仕事です。
Summary
皮膚T細胞性リンパ腫(CTCL)は非ホジキンリンパ腫で大半は菌状息肉症、一部はセザリー症候群。治療薬ベキサロテン(タルグレチンカプセル)はレチノイド(ビタミンA誘導体)で甲状腺ホルモンと同じくレチノイドX受容体(RXR)に結合。①視床下部・下垂体の甲状腺ホルモン受容体(TRβ)を活性化させ中枢性甲状腺機能低下症(視床下部・下垂体性甲状腺機能低下症)②1型、2型脱ヨード酵素阻害③甲状腺ホルモンの末梢分解促進をおこすため甲状腺ホルモン剤(チラージンS)予防的投与。菌状息肉症の抗がん剤治療後second primary cancerとして甲状腺癌が発生。
Keywords
皮膚T細胞性リンパ腫,菌状息肉症,セザリー症候群,治療,ベキサロテン,タルグレチン,レチノイド,甲状腺ホルモン,レチノイドX受容体,中枢性甲状腺機能低下症
皮膚T細胞性リンパ腫(CTCL:cutaneous T cell lymphoma)は稀な非ホジキンリンパ腫で、日本における新規患者は年間400人程に過ぎません。
皮膚T細胞性リンパ腫(CTCL)は、初診時において皮膚以外の臓器に病変を認めません。皮膚T細胞性リンパ腫(CTCL)の大半は菌状息肉症と言われるもので、放置すると10-20年後、多発性皮膚腫瘤から他臓器浸潤、感染症などを発症して極めて予後が悪くなります。
菌状息肉症は、病期により発疹が変化します。
最初の10-20年間は浸潤性紅斑期で、湿疹などが体幹・四肢に現れ、慢性湿疹やアトピー性皮膚炎と誤診されることが多い。
- ステロイド外用剤を処方されて、一端、治癒する事も多く、菌状息肉症がマスクされてしまう
- ステロイド外用剤の効きが悪い場合;
①多少効果あるも治癒しない
②免疫抑制剤のタクロリムス軟膏を使用すると、サイトカインのバランスが変わり、皮疹が悪化(鋭い皮膚科医なら菌状息肉症を見破ります。)
2.の場合は菌状息肉症を疑い、皮膚生検する必要があります。しかし、一度の生検では、炎症細胞浸潤のみでT細胞性リンパ腫細胞(異型リンパ球)を認めず、アトピー性皮膚炎との鑑別が難しいため、何度も行う事を前提にせねばなりません。
浸潤性紅斑は増悪・軽快を繰り返し拡大、やがて皮膚萎縮・色素沈着し、多型皮膚萎縮に至ります(菌状息肉症 腫瘍期)。
菌状息肉症の確定診断は皮膚生検ですが、病期により所見も異なります。
真皮浅層に帯状異型リンパ球浸潤を認め、表皮にも浸潤します。微小膿瘍を形成。抗CD4抗体の免疫染色陽性。(Modern Practices in Radiation Therapyより)
国内臨床試験で、副作用が全例に認められ(えらいこっちゃ)、
- (中枢性)下垂体性甲状腺機能低下症(93.8%);(下記)
- 高コレステロール血症(81.3%);肝細胞のレチノイドX受容体(RXR)に結合してコレステロール合成を促進
- 高トリグリセリド(中性脂肪)血症(75.0%);肝細胞のレチノイドX受容体(RXR)に結合してトリグリセリド合成を促進、膵炎を誘発する程の上昇も
- HDLコレステロールの減少(Med Clin (Barc). 2016 Feb 5;146(3):117-20.)
- 膵炎
- 低血糖
- 白血球減少症、好中球減少症(31.3%);ベキサロテン減量を要する
- 貧血(18.8%)
- 肝不全、肝機能障害
- 感染症
- 間質性肺疾患
- 横紋筋融解症
(J Dermatol. 2017 Feb;44(2):135-142.)
中枢性甲状腺機能低下症(視床下部・下垂体性甲状腺機能低下症)
視床下部・下垂体の甲状腺ホルモン受容体(TRβ)はレチノイドX受容体(RXR)の一種です。ベキサロテン(商品名タルグレチンカプセル)結合により活性化されれば、ネガティブフィードバック機構が働きます。結果、TSHβ鎖を合成する遺伝子のプロモーターにブレーキが掛かり、TSH合成が低下します[中枢性甲状腺機能低下症(視床下部・下垂体性甲状腺機能低下症)]。 [N Engl J Med. 1999 Apr 8;340(14):1075-9.]
また、ベキサロテンは、中枢性甲状腺機能低下症とは別経路で、
- 1型、2型脱ヨード酵素(DIO1,DIO2)も阻害(Eur J Endocrinol. 2014 Jun;170(6):R253-62.)
- 脱ヨード酵素を介さずに甲状腺ホルモンの末梢分解を促進[J Clin Endocrinol Metab. 2007 Jul;92(7):2496-9.]
するとされます。
甲状腺ホルモン剤(チラージンS)の予防的投与
ベキサロテン内服して、早ければ3日~7日後、4~5週間後まで(ほとんど1カ月以内)に甲状腺機能低下症に至るため、甲状腺ホルモン剤(チラージンS)の予防的投与も考慮すべきでしょう。[Clin Endocrinol (Oxf). 2019 Jul;91(1):195-200.](第60回 日本甲状腺学会 O6-6 わが国におけるベキサロテンによる中枢性甲状腺機能低下症の頻度と対策)(第61回 日本甲状腺学会O35-4 ベキサロテン内服開始3日後に中枢性甲状腺機能低下症をきたし た菌状息肉症の一例)
但し、甲状腺機能低下していない時期に行うと甲状腺中毒症をおこす危険もあるため、ベキサロテン投与前の甲状腺ホルモン値を確認の上、少量から始めるのが良いと思います。
甲状腺ホルモン剤(チラージンS)のコントロールは、中枢性甲状腺機能低下症なので、TSHでなくFT4、FT3を指標に行います。報告では通常の中枢性甲状腺機能低下症よりも高容量(通常用量の2倍)を必要とします(前述のごとく1型、2型脱ヨード酵素阻害と甲状腺ホルモンの末梢分解促進もあるため)。[Clin Endocrinol (Oxf). 2019 Jul;91(1):195-200.][Clin Lymphoma. 2003 Mar;3(4):249-52.][Clin Lymphoma. 2003 Mar;3(4):249-52.]
最初から甲状腺機能低下症/橋本病で甲状腺ホルモン剤(チラージンS)服薬中の場合
甲状腺機能低下症/橋本病で既に甲状腺ホルモン剤(チラージンS)服薬中の場合、増量が必要になります。
最初から甲状腺自体がほぼ完全に破壊され、下垂体の影響を受けなくても(最初からTSHに反応しない)、前述のごとく1型、2型脱ヨード酵素阻害と甲状腺ホルモン剤(チラージンS=合成T4)分解促進のため、増量の必要があります。
- 甲状腺全摘出後
- 甲状腺機能亢進症/バセドウ病のアイソトープ(放射性ヨウ素; I-131)治療後で完全に甲状腺組織が破壊された状態
- 甲状腺無形成による先天性甲状腺機能低下症
でも同じです。
ベキサロテン投与中止した場合、甲状腺ホルモン剤(チラージンS)はどうすれば良いか?
ベキサロテンの中止後1週間、遅くとも4週以内に甲状腺機能が改善するとされます。甲状腺ホルモン剤(チラージンS)は半減期が約 9~10 日なので、同時の中止が良いという事になります。(第60回 日本甲状腺学会 P1-6-1 ベキサロテンによる中枢性甲状腺機能低下症を認めた1例)(British Association of Dermatologists 168: 192-200, 2013)
中枢性甲状腺機能低下症に続いて甲状腺機能亢進症/バセドウ病を発症
生成AIを用いると"Bexarotene, a retinoid medication used to treat cutaneous T-cell lymphoma (CTCL), can cause central hypothyroidism, which can lead to Graves' disease (GD) thyrotoxicosis."との結論になりますが、PubMedでそのような報告は1例もありません(2024.10現在)。
しかしながら、ベキサロテン投与後の中枢性甲状腺機能低下症に続いて甲状腺機能亢進症/バセドウ病を発症した報告があります(東邦大学が報告)。(第67回 日本甲状腺学会 P1-2 ベキサロテン投与による中枢性甲状腺機能低下症を認めた後にバセドウ病を発症した一例)
ステロイド(副腎皮質ホルモン)剤の長期使用による副腎の廃用性萎縮を合併している
菌状息肉症(皮膚T細胞性リンパ腫)では、すべての病期でステロイド外用を推奨されており、ステロイド(副腎皮質ホルモン)による視床下部・下垂体抑制からACTHとコルチゾールは低下しています。
ステロイド(副腎皮質ホルモン)外用剤は体内に吸収されるため、長期使用で副腎が廃用性萎縮します。そのため、迅速ACTH負荷試験に反応しません。
ステロイド(副腎皮質ホルモン)剤が体内にあるため、甲状腺ホルモン剤(チラージンS)投与で即、副腎クリーゼ(急性副腎不全)にはなりません。
菌状息肉症治療の基本は紫外線療法(PUVA療法、ナローバンドUVBなど)で、他臓器浸潤する前(病初期10-20年の間)に治療開始すれば、生命予後は悪化しないとされます。
菌状息肉症の抗がん剤治療とPUVA療法を施行した後に、second primary cancerとして甲状腺癌と前立腺癌の合併が発見された症例報告あり。菌状息肉症の細胞性免疫能低下状態において、化学療法・放射線療法が何らかの影響を与えた可能性が考えられます。 [西日本皮膚科 Vol. 62 (2000) No. 3 P 317-320]
セザリー症候群は、菌状息肉症と同じく、皮膚T細胞性リンパ腫(CTCL)の一種です。50〜60歳以上の高齢者に好発。発熱、リンパ節腫脹、全身に痒みを伴う発赤(紅皮症)が出現。末梢血液中には、Tリンパ球細胞癌特有のくびれの深い核を持つ異型Tリンパ球(セザリー細胞)を認めます。
甲状腺関連の上記以外の検査・治療 長崎甲状腺クリニック(大阪)
長崎甲状腺クリニック(大阪)とは
長崎甲状腺クリニック(大阪)は日本甲状腺学会認定 甲状腺専門医[橋本病,バセドウ病,甲状腺超音波(エコー)検査など]による甲状腺専門クリニック。大阪府大阪市東住吉区にあります。平野区,住吉区,阿倍野区,住之江区,松原市,堺市,羽曳野市,八尾市,東大阪市,浪速区,天王寺区,生野区も近く。